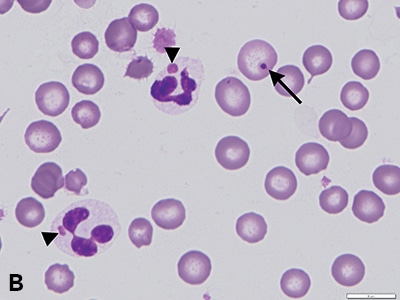
<p>what is this</p>
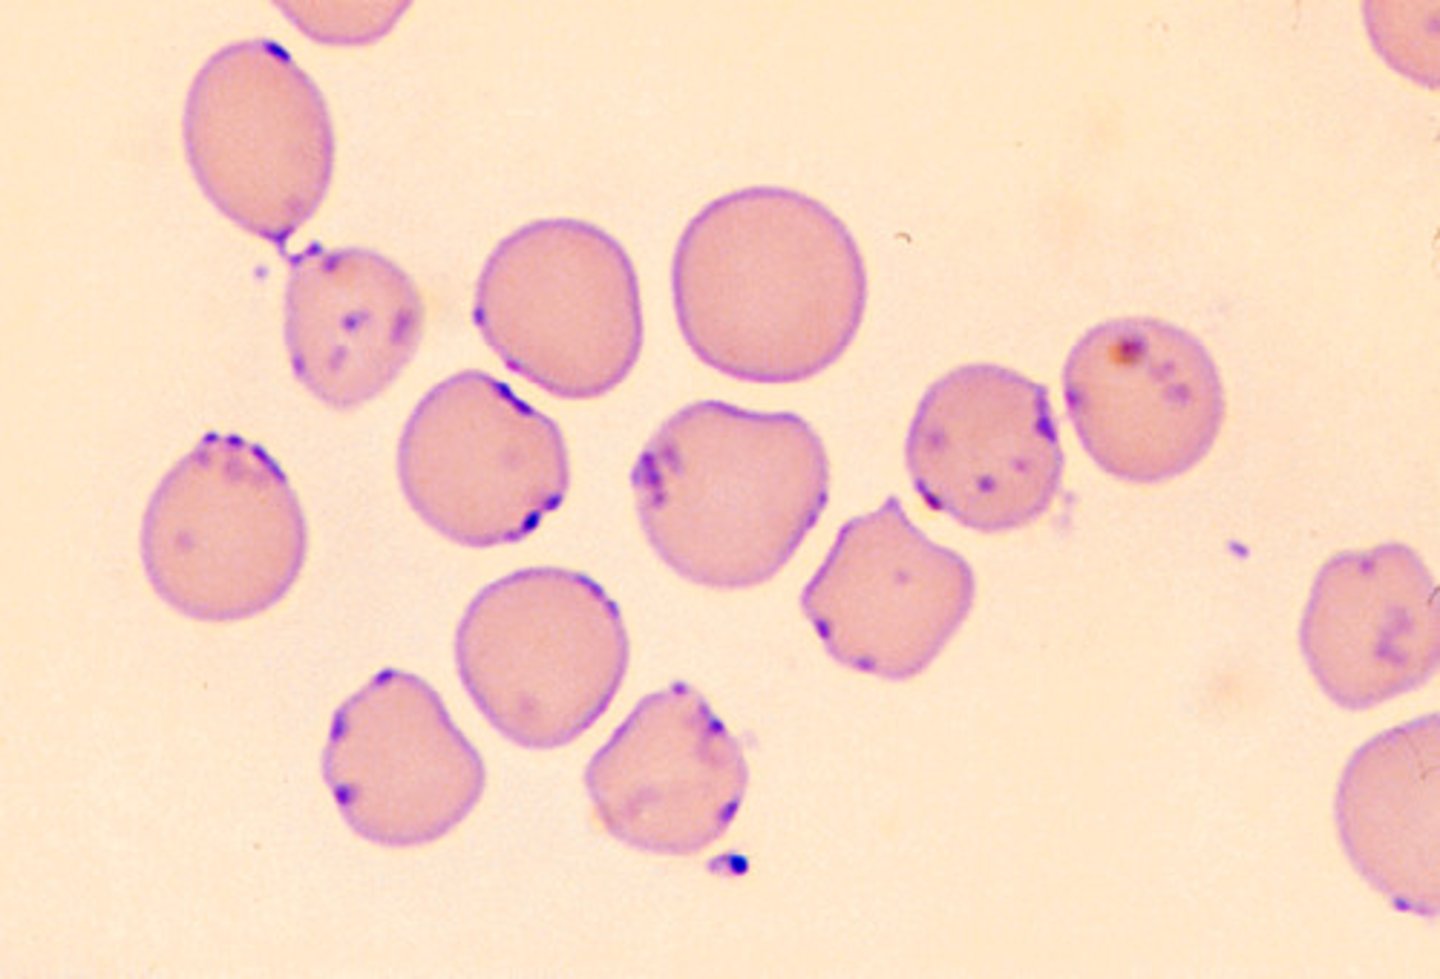
<p>what is this</p>
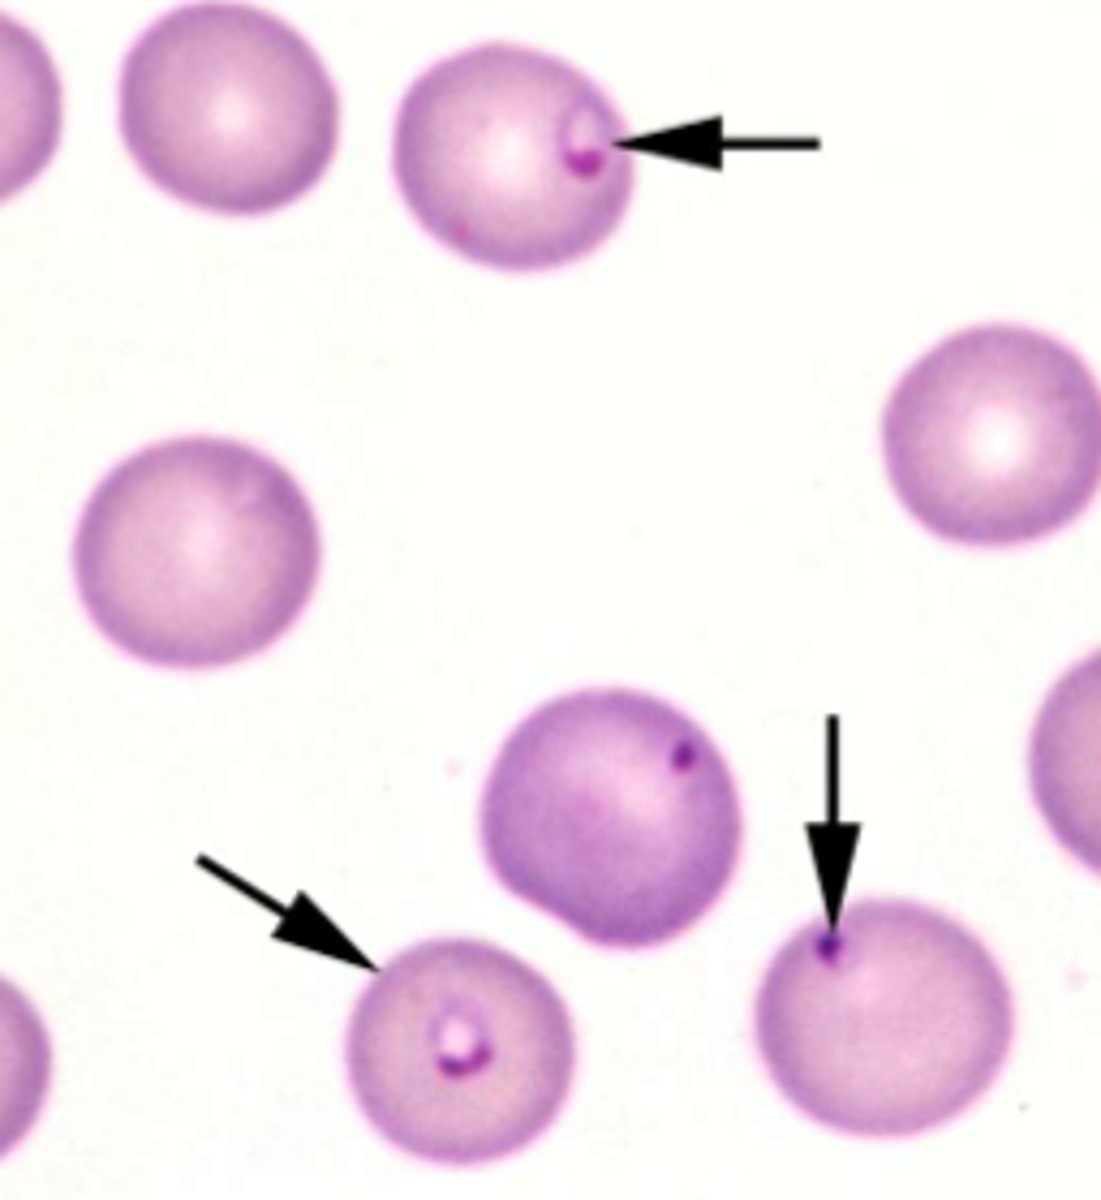
<p>what is this</p>
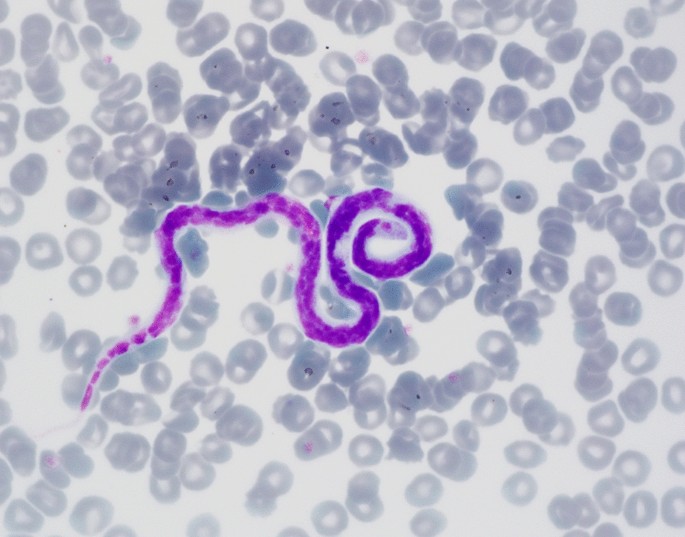
<p>what is this</p>
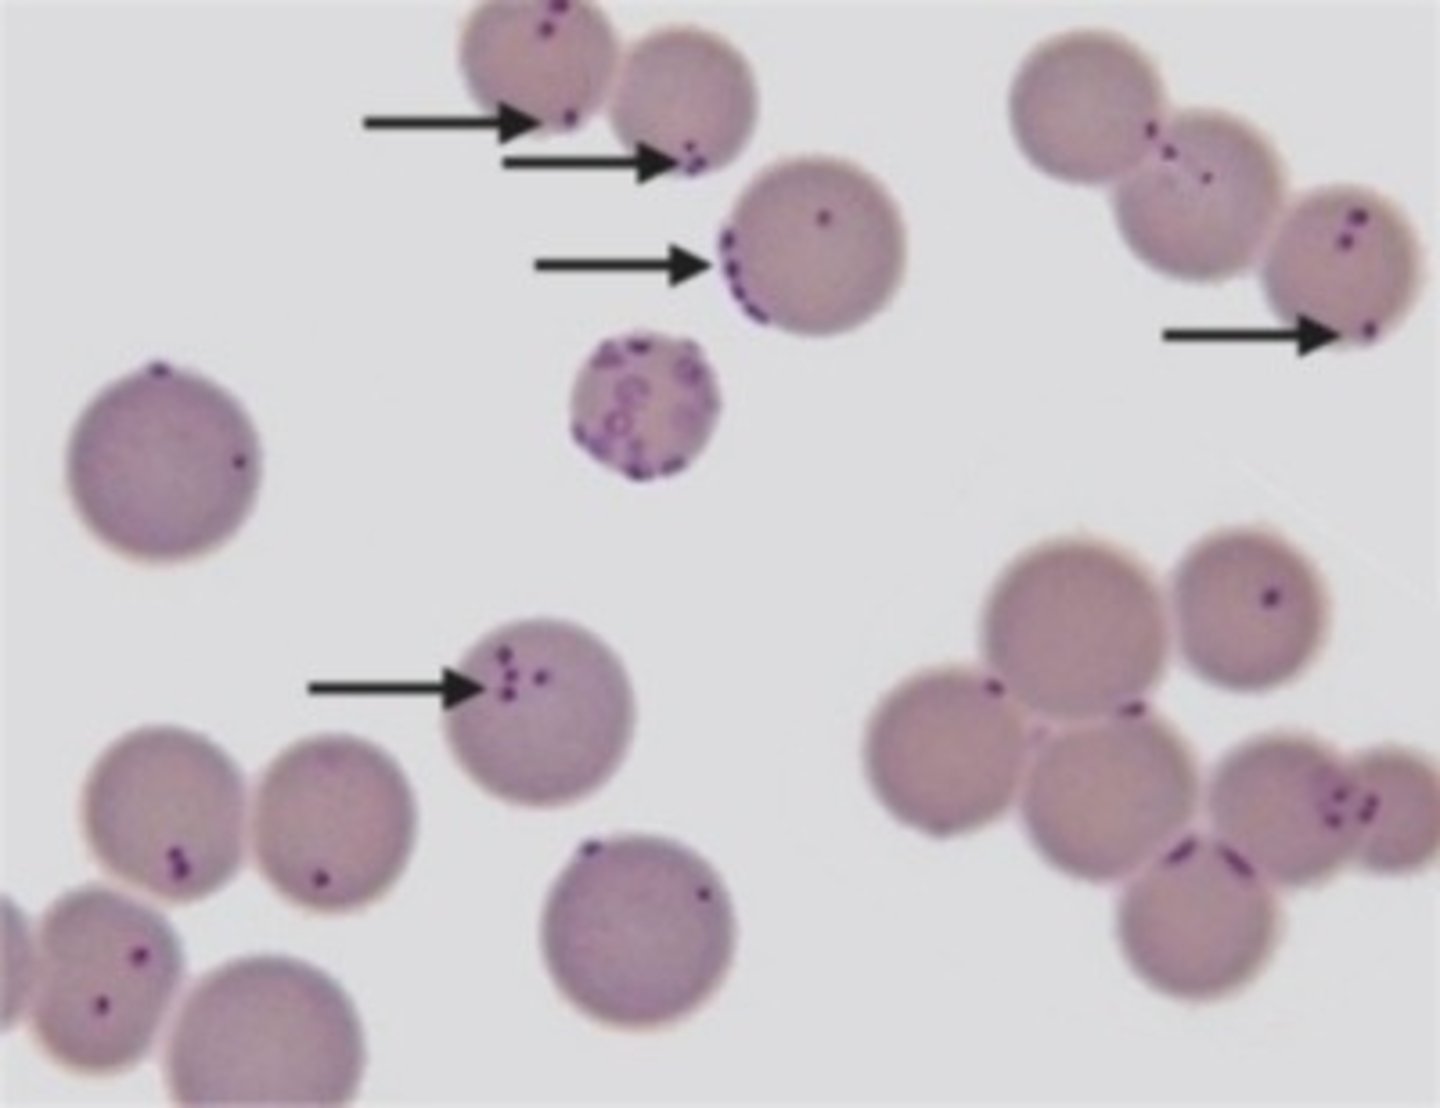
<p>what is this</p>

Parasite ID review
1/21
There's no tags or description
Looks like no tags are added yet.
Name | Mastery | Learn | Test | Matching | Spaced | Call with Kai |
|---|
No analytics yet
Send a link to your students to track their progress
22 Terms

what is this
Anaplasma marginale
what is this
canine distemper virus inclusion bodies
what is this
Mycoplasma haemofelis

what is this
Babesia canis
what is this
Cytauxzoon felis

what is this
Erlichia
what is this
dirofilaria immitis (heartworm)

what is this
Giardia

what is this
Pinworm

what is this
pinworm ova

what is this
coccida

what is this
Trichuris vulpis (whipworm)

what is this
Ancylostoma caninum (hookworm)

what is this
Toxocara canis (roundworm)

what is this
Dipylidium caninum (tapeworm)

what is this
Demodex canis

what is this
Cheyletiella blakei

what is this
sarcoptes scabiei

what is this
otodectes cynotis (ear mite)
what is this
Mycoplasma haemoncanis

what is this
Pearsonema plica (bladder roundworm of dogs and cats)

What is this
Dioctophyma renale (kidney roundworm of dogs)